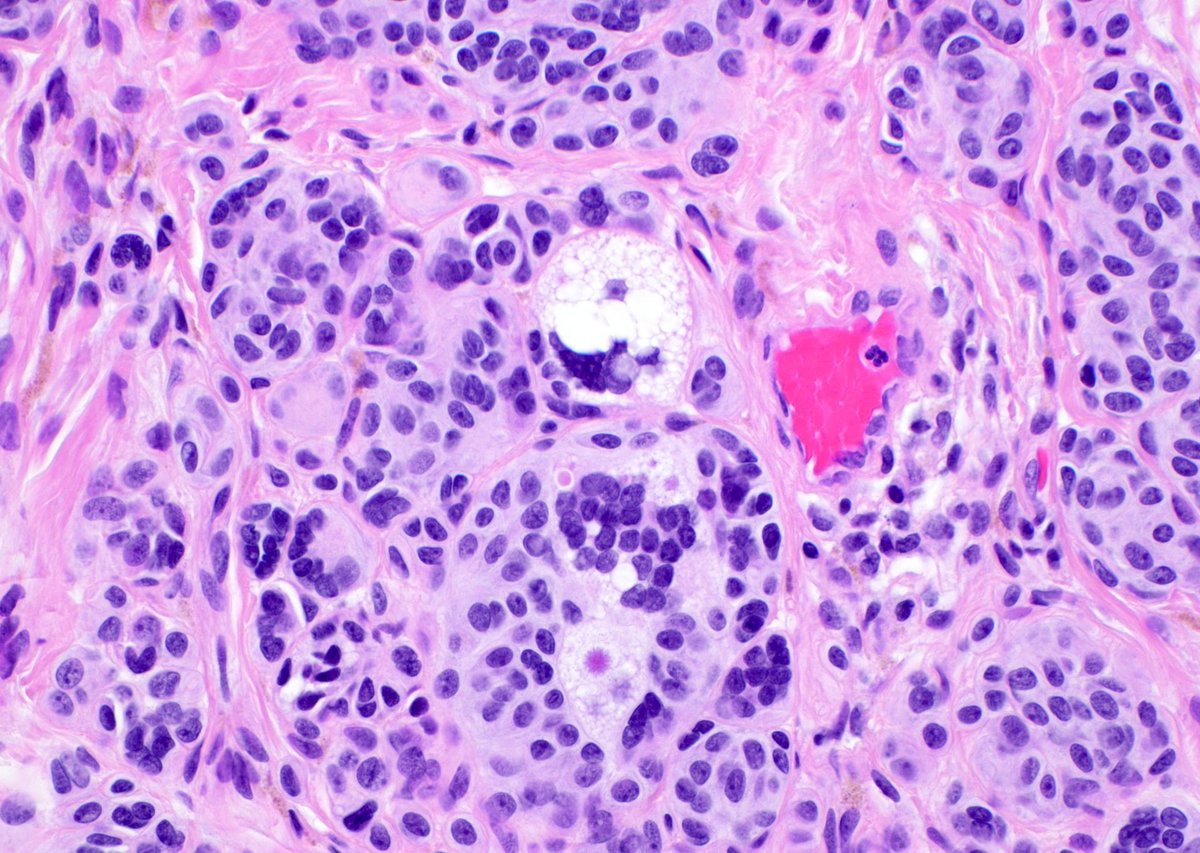
JMGardnerMD's tweet image. What are the bubbly cells? (hint: they&apos;re NOT sebocytes or lipoblasts!) 
What is the pink dot in the cytoplasm? Diagnosis?
Answers ✅ youtu.be/DqLK6ZvNXTU 
#pathology #pathologists #pathTwitter #dermpath #dermatology #dermatologia #dermtwitter
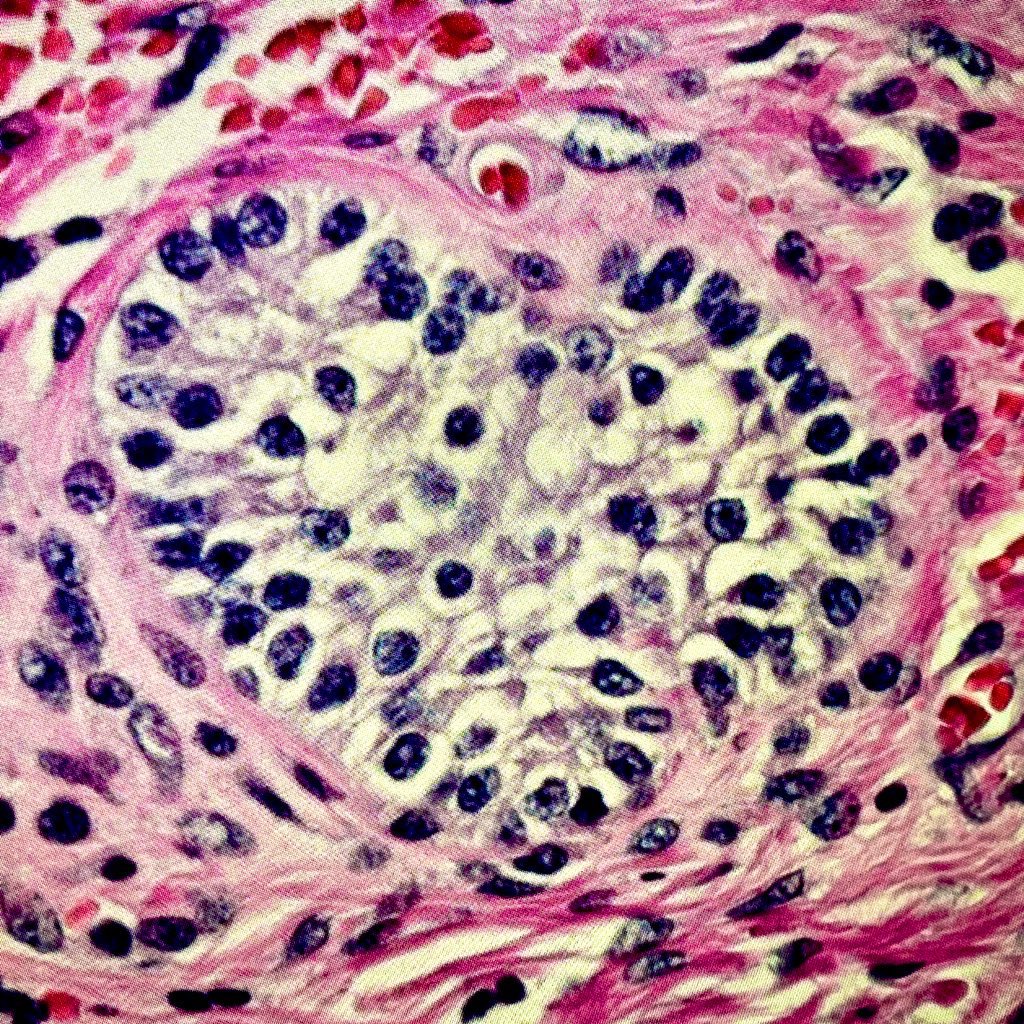
vetpathnerd's tweet image. #HappyMothersDay #Pathart #OvarianPath
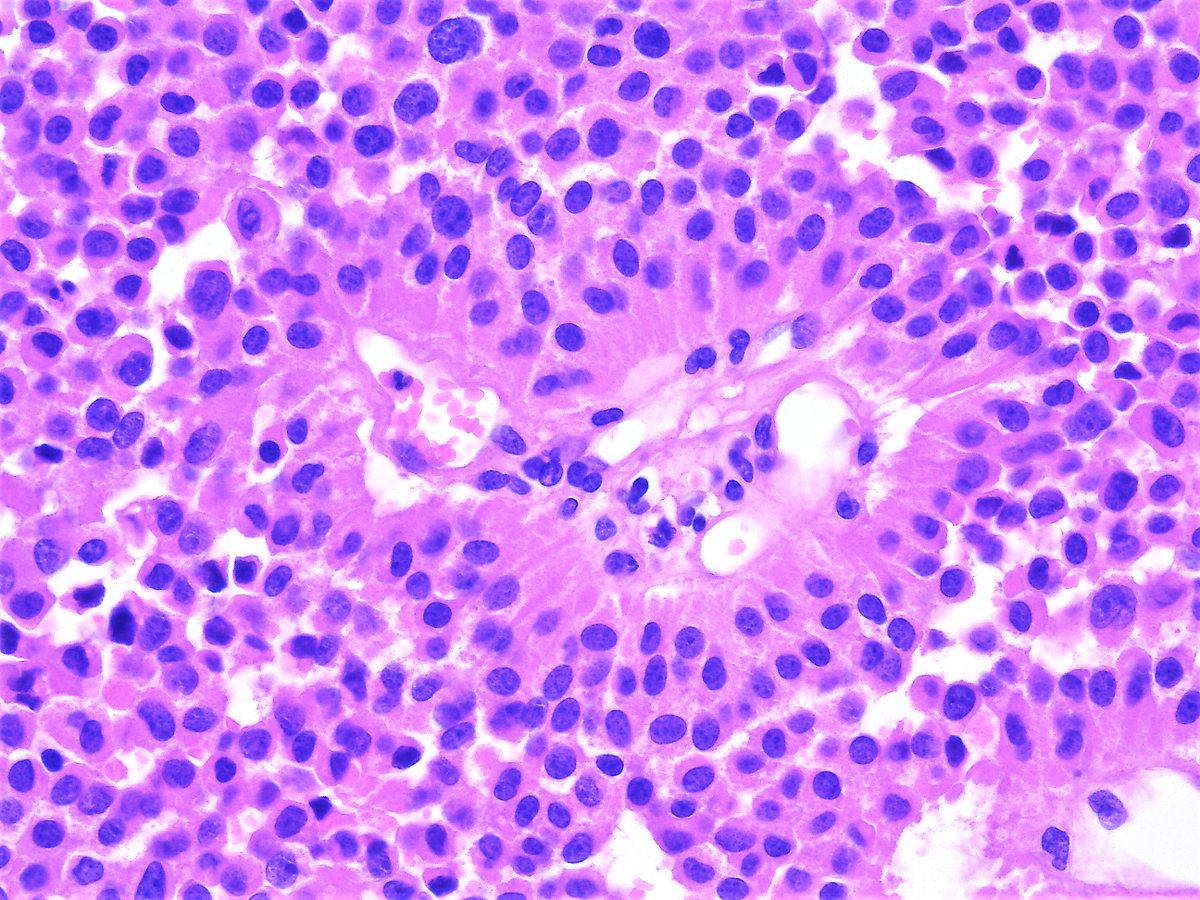
Patholwalker's tweet image. Pituitary adenoma. Pituitary gland, hypophysectomy. HE and lutenizing hormon. #pathology #Neuropath #Endopath
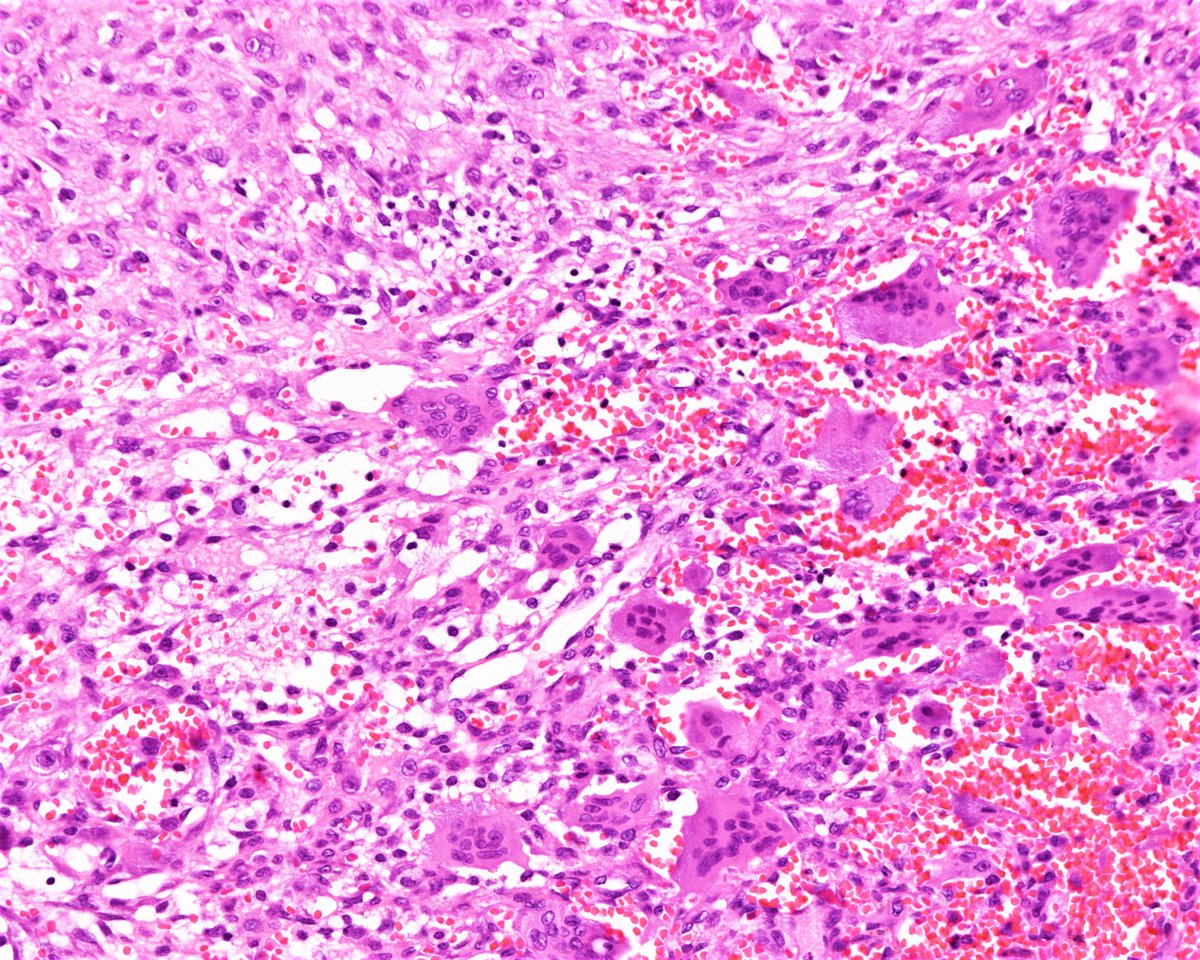
Patholwalker's tweet image. Aneurysmal bone cyst. Humeral bone, curettage. HE stain. #pathology #BSTpath

Cara Levine (Pillitteri)
@vetpathnerd
Veterinary Anatomic Pathologist (DACVP), diagnostic, domestic & exotic. ❤️ my job. RT does not = agreement/endorsement/advice
قد يعجبك
Best part of this job is that I get to help make pathology better for pathologists.
Still my favorite 3D reconstruction of a pancreatic tissue. Using the CODA workflow, we mapped a billion individual cells in 3D. Red: pre-cancer lesions Navy blue: ducts Light blue: islets of Langerhans Purple: acini Green: blood vessels More here: nature.com/articles/s4158…
Hypertrophic Cardiomyopathy - You Can’t Miss These Facts

Young athlete collapses mid-game Autopsy shows this Diagnosis?

A Patient with Cardiomyopathy died. What is the diagnosis⁉️ What is the Circled lesion ⁉️

What are the bubbly cells? (hint: they're NOT sebocytes or lipoblasts!) What is the pink dot in the cytoplasm? Diagnosis? Answers ✅ youtu.be/DqLK6ZvNXTU #pathology #pathologists #pathTwitter #dermpath #dermatology #dermatologia #dermtwitter
WHO classification of skin tumours: key updates in the fifth edition - Goldman‐Lévy - Histopathology - Wiley Online Library #dermpath #WHO #openaccess onlinelibrary.wiley.com/doi/10.1111/hi…
Calling Team #VetPath!
Can you make a #diagnosis of this tumor with nothing but a single H&E image? (Coming from me, at least you can reasonably assume it’s #neuropath related!). 🧠🔬

Puncture of the cervical lymph node...

Giraffe skin disease: Clinicopathologic characterization of cutaneous filariasis in the critically endangered Nubian giraffe @VetPathSurrey @LauraSetyo @olkazuraw @priya_sharp @vetpathnerd What is an interesting disease you've diagnosed? #vetpath pubmed.ncbi.nlm.nih.gov/35311406/
Covid-19 lung, H&E
Can you make a #diagnosis of this tumor with nothing but a single H&E image? (Coming from me, at least you can reasonably assume it’s #neuropath related!). 🧠🔬

Squamous cell carcinoma, well differentiated type. External ear canal, resection. #pathology #ENTpath




Leiomyosarcoma. Soft tissue, resection. HE and Caldesmon. #pathology #BSTpath




Pituitary adenoma. Pituitary gland, hypophysectomy. HE and lutenizing hormon. #pathology #Neuropath #Endopath

Aneurysmal bone cyst. Humeral bone, curettage. HE stain. #pathology #BSTpath

Medulloblastoma, NOS, WHO grade IV. Cerebellum, tumorectomy. HE and GFAP. #pathology #neuropath




United States الاتجاهات
- 1. Michigan 105K posts
- 2. Jeremiah Smith 4,907 posts
- 3. Ryan Day 4,530 posts
- 4. Buckeyes 7,978 posts
- 5. #TheGame 3,345 posts
- 6. #GoBlue 7,568 posts
- 7. Bo Jackson 1,254 posts
- 8. Malachi Toney N/A
- 9. Stoops 1,817 posts
- 10. Barham 1,535 posts
- 11. Sayin 85.5K posts
- 12. Florida 102K posts
- 13. Texas 187K posts
- 14. Donaldson 1,608 posts
- 15. Touchback 4,385 posts
- 16. #OSUvsMICH N/A
- 17. #SmallBusinessSaturday 3,106 posts
- 18. #GoBucks 4,944 posts
- 19. Kentucky 17.4K posts
- 20. Gus Johnson N/A
Something went wrong.
Something went wrong.

























































































































